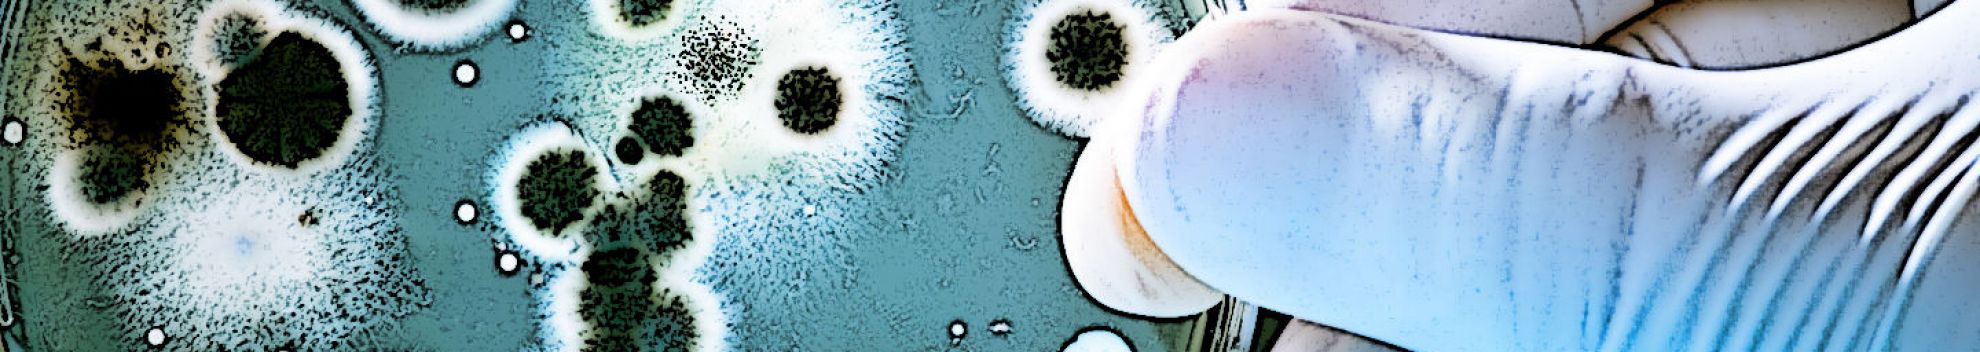

A estas cifras se suman más de 400 reuniones “1-to-1”, además de la participación de representantes de cinco gobiernos nacionales y de las cinco asociaciones nacionales de fondos de inversión, asociaciones de startups, tres agencias nacionales de inversión y un amplio número de medios de comunicación internacionales.
El broche de oro de esta gira tuvo lugar con el evento Startup OLÉ – Chile, en el que participaron representantes institucionales como Stefanie Sherman, gerente en Digevo Ventures y Vicepresidenta de ACVC -Asociación Chilena de Venture Capital y Francesca Lasagna, directora de Innovación de ProChile, que inauguraron el evento.
Asimismo, participaron Sebastián Pillado, director de ProChile España; Beatriz Herrera, coordinadora Red Internacional de InvestChile; Cecilia Valdés, gerente de Asuntos Corporativos de Corfo; David Fernández, subgerente de Start-Up Chile y Esteban Campero, asesor de PYMEs y Emprendimiento de la SEGIB -Secretaría General Iberoamericana-, así como Erik Díaz, CEO de Blackshiip VC; Gonzalo Soriano, inversor de Capital de Riesgo en AC Ventures (ACV_VC) y Sofia del Sante, Representante de Comercio e Innovación en Múnich de ProChile.
